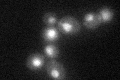
YKL022C
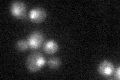
YKL022C

View description
Subunit of the anaphase-promoting complex/cyclosome (APC/C), which is a ubiquitin-protein ligase required for degradation of anaphase inhibitors, including mitotic cyclins, during the metaphase/anaphase transition; required for sporulation
Localization:
Intensity:
Fold change:
Significance:
-
C’ GFP library in SD
nucleus29.81 -
N' NOP1pr-GFP in SD

nucleus26.8418 -
N' TEF2pr-mCherry in SD

punctate,nucleus9.88087 -
N' NATIVEpr-GFP in SD

missing0 -
N' TEF2pr-VC and Cyto-VN in SD

below threshold23.4269 -
C’ GFP library in SD+DTT

punctate, nucleusN/AN/ANo -
C’ GFP library in SD+H2O2
nucleus30.711.03No -
C’ GFP library in Starvation Media

nucleus19.890.66Yes -
C’ GFP library on the background of Pup2-DaMP

nucleus -
C’ GFP library on the background of CCT mutant

nucleus33.5311.12457No
